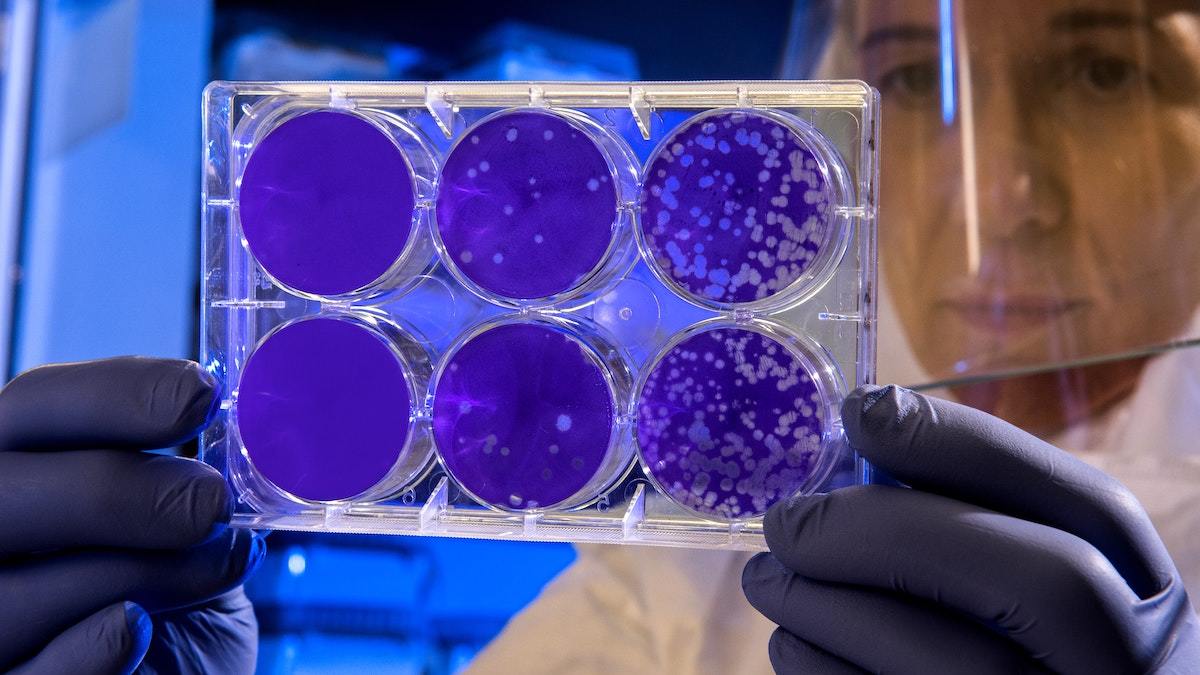

Western Michigan University Homer Stryker M.D. School of Medicine
Recent News About Western Michigan University Homer Stryker M.D. School of Medicine
-
How many H-1B petitions approved for employers classified under the Educational Services industry in Kalamazoo Times publication area during 2024?
In 2024, 100% of H-1B petitions filed by Educational Services employers across Kalamazoo Times publication area were approved, according to data from the U.S. Citizenship and Immigration Services via the H-1B Employer Data Hub.
-
How many H-1B petitions made by employers in Kalamazoo Times publication area were approved during 2024?
In 2024, 97.9% of H-1B petitions filed by employers in the Kalamazoo Times publication area were approved, according to data from the U.S. Citizenship and Immigration Services via the H-1B Employer Data Hub.
-
Employers in Kalamazoo Times publication area filed 96 H-1B petitions throughout 2024
In 2024, 96 H-1B petitions were filed by employers located in the Kalamazoo Times publication area, as per data provided by the U.S. Citizenship and Immigration Services via the H-1B Employer Data Hub.
-
Educational Services industry employers submit 29 H-1B petitions across Kalamazoo Times publication area in 2024
Employers classified under the Educational Services industry based in the Kalamazoo Times publication area submitted 29 H-1B petitions during 2024, according to data provided by the U.S. Citizenship and Immigration Services via the H-1B Employer Data Hub.
-
84.1% of college applicants to Kalamazoo County's 7 universities were admitted for fall 2022
Kalamazoo County's seven universities admitted an estimated 84.1% of applicants for fall 2022, an increase over the previous year.
-
WMU creates protective gear for health care workers responding to COVID-19
COVID-19 continues to spread at alarming rates, but the national stockpile of medical safety equipment continues to be depleted.
-
Graduates earn 50 degrees, certificates from Western Michigan University Homer Stryker M.D. School of Medicine
About 98 percent of the 50 degrees and certificates handed out by Western Michigan University Homer Stryker M.D. School of Medicine in 2017-18 were to students in health professions and related programs, making them the most popular programs that year, according to the latest disclosure from the U.S. Department of Education.